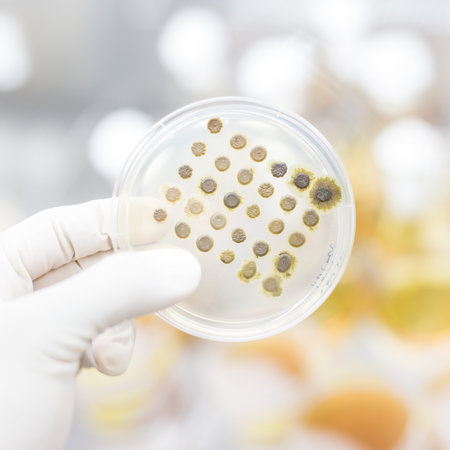
Scientist growing bacteria in petri dishes on agar gel as a part of scientific experiment.の写真素材

写真素材 - Scientist growing bacteria in petri dishes on agar gel as a part of scientific experiment.
作品情報
Scientist growing bacteria in petri dishes on agar gel as a part of scientific experiment.
- ID:259779833
- 作品種別:写真
- 作者名:Matej Kastelic
キーワード
- agar
- analysis
- analyze
- bacteria
- bacteriology
- bacterium
- biochemistry
- biological
- biology
- cell
- culture
- drug
- experiment
- fungi
- fungus
- grow
- health care
- healthcare
- infectious
- laboratory
- medical
- medicine
- micro
- micro organism
- microbe
- microbiology
- pandemic
- pathogen
- pathology
- petri dish
- plate
- research
- science
- scientific
- strain
- technology
- test
- transparent
- treatment
- virus
類似作品
Young male chem...
Hands hold Petr...
Laboratory tech...
epidemic and th...
Backgrounds of ...
A researcher in...
Young serious b...
Young male chem...
Research of vir...
Laboratory tech...
Chemist working...
Word biohazard ...
Laboratory tech...
Gloved hands of...
Hand in glove h...
Hands holding a...
Uncovering the ...
Senior life sci...
Hands in gloves...
Research of vir...
Two Petri dishe...
Laboratory tech...
chemist wearing...
Scientist analy...
Young male chem...
close up. a fem...
Focused senior ...
Scientist exami...
Hands hold Petr...
microbiologist ...
A researcher ca...
Research labora...
Scientific hand...
Hand in blue gl...
lab technician ...
Scientist holdi...
Melioidosis sic...
Unrecognizable ...
Colony Characte...
group of scient...
Gloved Hand of ...
Focused senior ...
bacterial colon...
Gloved hand of ...
Female research...
Laboratory tech...
Scientific Rese...
Close-up of bac...
Microbiologist ...